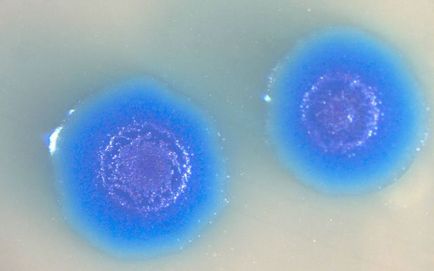

Створено першу комп'ютерну модель живого організму
Каліфорнійські дослідники недавно повідомили, ні багато ні мало, про справжній прорив в області так званої обчислювальної біології. Скромності американським вченим не позичати, проте їх роботу дійсно можна назвати проривом! Повідомляється, що їм вдалося створити комп'ютерну модель живого організму.
Для створення подібної моделі, фахівці об'єднали воєдино дані, отримані в результаті дев'ятисот наукових робіт. Їм довелося прорахувати всі молекулярні взаємодії життєвого циклу ... ні, звичайно, не людину, а всього лише однією з найменших бактерій під назвою Mycoplasma genitalium.
Виявляється, що мова йде про паразитує вигляді бактерії, який був виділений зі зразка тканин пацієнтів, які страждають від специфічного захворювання уретри. Таким чином, цей мікроорганізм, все ж, має певне відношення до людини. Насправді, мова йде не про якийсь там тамагочі, якого треба вчасно "годувати" та "виводити пописати", а про першу повної комп'ютерної моделі живого організму, нехай і одного з найпростіших (хоча віруси є ще більш простими, але самостійними організмами).
Взагалі, моделювання цілісного живого організму протягом багатьох років було головним завданням обчислювальної біології. Насправді, це чергова сходинка до удосконалення комп'ютерних програм таким чином, щоб вони були здатні допомагати вченим в питаннях біоінженерії та медицини. Втім, навряд чи хтось серйозно вірить в те, що ці ж роботи не є також ступенем для створення штучного інтелекту. Адже саме так, за принципом "від простого до складного", вчені і мають намір рухатися далі в своїх наукових роботах.

Треба сказати, що створення комп'ютерної моделі, про яку йде мова в даній статті, стало можливо завдяки величезній кількості інформації про клітинах, накопиченому за останні два десятиліття. Тепер вчені не зможуть поскаржитися на брак первинних даних, як це було раніше. Дослідники повідомили також, що обраний для створення комп'ютерної моделі організм містить всього 525 генів, в той час як інші подібні організми мають кілька тисяч генів.

На тлі даної події, згадується нещодавня новина про створення штучної медузи, яка, по суті, є першим найпростішим біологічним роботом. Що ж нас очікує в більш віддаленому майбутньому? Невже ті самі біологічні та кібернетичні організми, які, як припускали багато, заполонять Землю і витіснять людство? Адже, схоже на те, що люди дійсно наближаються до створення штучного інтелекту! Здається, найсміливіші пророцтва фантастів скоро почнуть збуватися ...